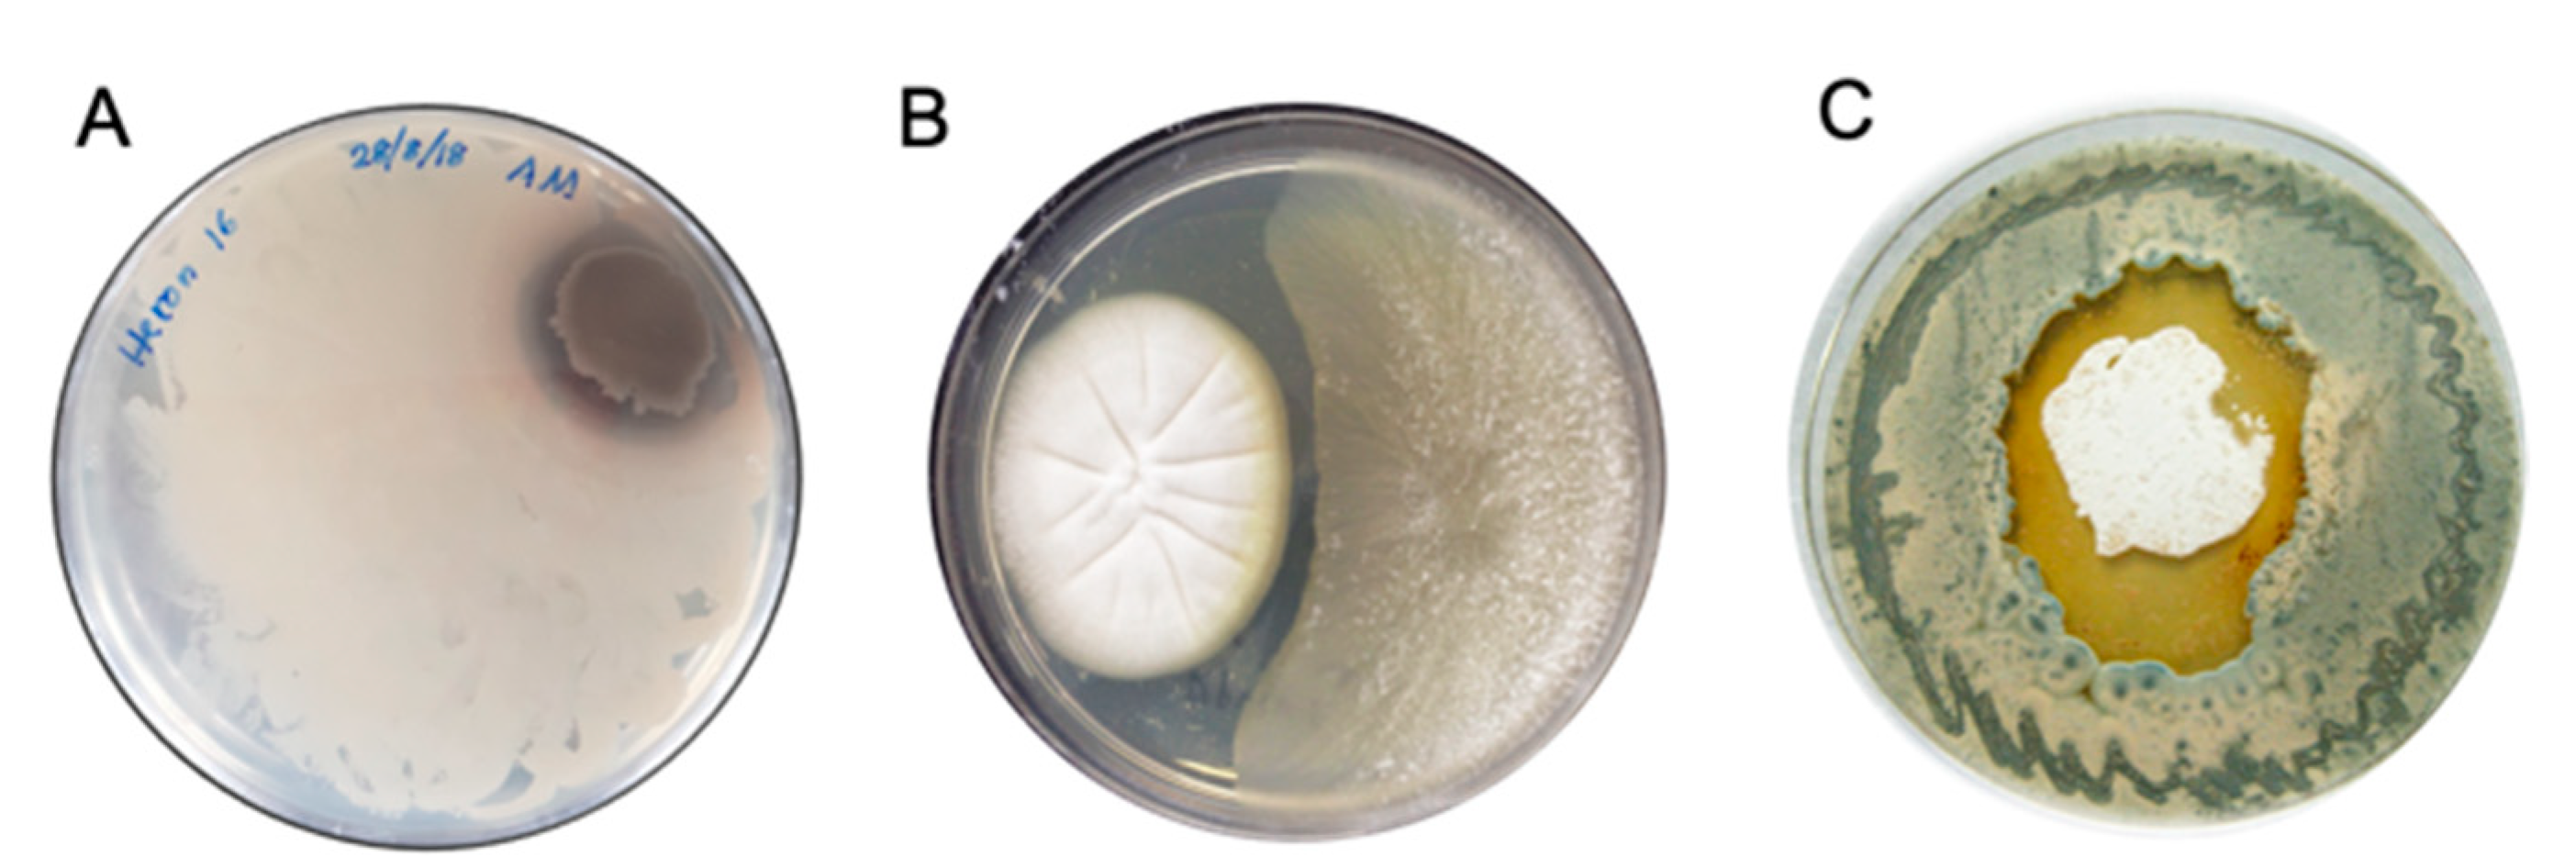
Marinedrugs 19 00503 g003 550

Methods in Microbial Biodiscovery
Abstract
:1. Introduction
2. Microbial Diversity
2.1. Substrate Diversity
2.1.1. Examples of Terrestrial Substrates and Microbes
2.1.2. Examples of Marine Substrates and Microbes
2.2. Microbial Isolation
2.2.1. Substrate Processing
2.2.2. Cultivation Conditions
2.2.3. Recovering Pure Isolates
2.3. Microbial Preservation
2.4. Microbial Taxonomy
3. Transcriptional Activation
3.1. Silent Chemical Defences
3.2. Co-Cultivation
3.3. Natural Chemical Cues
- (i)
- Activation—leading to the production of otherwise silent metabolites.
- (ii)
- Enhancement—increasing the levels of production of otherwise minor metabolites.
- (iii)
- Acceleration—significantly decreasing the time taken to production of metabolites
- (iv)
- Suppression—shutting down the production of metabolites.
4. Biological Profiling
4.1. Bioactives
4.2. Bioassays
4.2.1. Key Bioassays Consideration
4.2.2. Outsourcing through Collaboration
4.3. Examples of Bioactive Compounds Characterised in Our Lab
5. Chemical Profiling
5.1. Dereplication
5.2. UPLC–DAD and HPLC–DAD–MS
5.3. Molecular Networking
6. Cultivation Profiling
6.1. Media Matrix
6.2. Large-Scale Cultivation
7. Microbial Natural Products
7.1. Extraction
7.2. Fractionation
7.3. Structure Elucidation
7.4. Artifacts
8. Future of Microbial Biodiscovery
Author Contributions
Funding
Acknowledgments
Conflicts of Interest
References
- Khalil, Z.G.; Salim, A.A.; Lacey, E.; Blumenthal, A.; Capon, R.J. Wollamides: Antimycobacterial Cyclic Hexapeptides from an Australian Soil Streptomyces. Org. Lett. 2014, 16, 5120–5123. [Google Scholar] [CrossRef]
- Khalil, Z.G.; Hill, T.A.; De Leon Rodriguez, L.M.; Lohman, R.-J.; Hoang, H.N.; Reiling, N.; Hillemann, D.; Brimble, M.A.; Fairlie, D.P.; Blumenthal, A.; et al. Structure-Activity Relationships of Wollamide Cyclic Hexapeptides with Activity against Drug-Resistant and Intracellular Mycobacterium tuberculosis. Antimicrob. Agents Chemother. 2019, 63, e01773-18. [Google Scholar] [CrossRef] [PubMed] [Green Version]
- Quezada, M.; Shang, Z.; Kalansuriya, P.; Salim, A.A.; Lacey, E.; Capon, R.J. Waspergillamide a, a Nitro Depsi-Tetrapeptide Diketopiperazine from an Australian Mud Dauber Wasp-Associated Aspergillus sp. (CMB-W031). J. Nat. Prod. 2017, 80, 1192–1195. [Google Scholar] [CrossRef] [PubMed]
- Elbanna, A.H.; Khalil, Z.G.; Bernhardt, P.V.; Capon, R.J. Neobulgarones Revisited: Anti and Syn Bianthrones from an Australian Mud Dauber Wasp Nest-Associated Fungus, Penicillium sp. CMB-MD22. J. Nat. Prod. 2021, 84, 762–770. [Google Scholar] [CrossRef]
- Jiao, W.-H.; Dewapriya, P.; Mohamed, O.; Khalil, Z.G.; Salim, A.A.; Lin, H.-W.; Capon, R.J. Divirensols: Sesquiterpene Dimers from the Australian Termite Nest-Derived Fungus Trichoderma virens CMB-TN16. J. Nat. Prod. 2019, 82, 87–95. [Google Scholar] [CrossRef] [PubMed]
- Jiao, W.-H.; Salim, A.A.; Khalil, Z.G.; Dewapriya, P.; Lin, H.-W.; Butler, M.S.; Capon, R.J. Trivirensols: Selectively Bacteriostatic Sesquiterpene Trimers from the Australian Termite Nest-Derived Fungus Trichoderma Virens CMB-TN16. J. Nat. Prod. 2019, 82, 3165–3175. [Google Scholar] [CrossRef]
- Raju, R.; Piggott, A.M.; Conte, M.M.; Capon, R.J. Heronamides A-C, New Polyketide Macrolactams from an Australian Marine-Derived Streptomyces sp.: A Biosynthetic Case for Synchronized Tandem Electrocyclization. Org. Biomol. Chem. 2010, 8, 4682–4689. [Google Scholar] [CrossRef] [PubMed]
- Booth, T.J.; Alt, S.; Capon, R.J.; Wilkinson, B. Synchronous Intramolecular Cycloadditions of the Polyene Macrolactam Polyketide Heronamide C. Chem. Commun. 2016, 52, 6383–6386. [Google Scholar] [CrossRef] [Green Version]
- Raju, R.; Khalil, Z.G.; Piggott, A.M.; Blumenthal, A.; Gardiner, D.L.; Skinner-Adams, T.S.; Capon, R.J. Mollemycin A: An Antimalarial and Antibacterial Glyco-Hexadepsipeptide-Polyketide from an Australian Marine-Derived Streptomyces sp. (CMB-M0244). Org. Lett. 2014, 16, 1716–1719. [Google Scholar] [CrossRef]
- Shang, Z.; Khalil, Z.; Li, L.; Salim, A.A.; Quezada, M.; Kalansuriya, P.; Capon, R.J. Roseopurpurins: Chemical Diversity Enhanced by Convergent Biosynthesis and Forward and Reverse Michael Additions. Org. Lett. 2016, 18, 4340–4343. [Google Scholar] [CrossRef] [PubMed]
- Dewapriya, P.; Prasad, P.; Damodar, R.; Salim, A.A.; Capon, R.J. Talarolide a, a Cyclic Heptapeptide Hydroxamate from an Australian Marine Tunicate-Associated Fungus, Talaromyces sp. (CMB-TU011). Org. Lett. 2017, 19, 2046–2049. [Google Scholar] [CrossRef]
- Elbanna, A.H.; Khalil, Z.G.; Bernhardt, P.V.; Capon, R.J. Chrysosporazines A-E: P-Glycoprotein Inhibitory Piperazines from an Australian Marine Fish Gastrointestinal Tract-Derived Fungus, Chrysosporium sp. CMB-F214. Org. Lett. 2019, 21, 8097–8100. [Google Scholar] [CrossRef] [PubMed]
- Mohamed, O.G.; Salim, A.A.; Khalil, Z.G.; Elbanna, A.H.; Bernhardt, P.V.; Capon, R.J. Chrysosporazines F-M: P-Glycoprotein Inhibitory Phenylpropanoid Piperazines from an Australian Marine Fish Derived Fungus, Chrysosporium sp. CMB-F294. J. Nat. Prod. 2020, 83, 497–504. [Google Scholar] [CrossRef] [PubMed]
- Quezada, M.; Licona-Cassani, C.; Cruz-Morales, P.; Salim, A.A.; Marcellin, E.; Capon, R.J.; Barona-Gómez, F. Diverse Cone-Snail Species Harbor Closely Related Streptomyces Species with Conserved Chemical and Genetic Profiles, Including Polycyclic Tetramic Acid Macrolactams. Front. Microbiol. 2017, 8, 2305. [Google Scholar] [CrossRef] [PubMed]
- Shang, Z.; Salim, A.A.; Capon, R.J. Chaunopyran A: Co-Cultivation of Marine Mollusk-Derived Fungi Activates a Rare Class of 2-Alkenyl-Tetrahydropyran. J. Nat. Prod. 2017, 80, 1167–1172. [Google Scholar] [CrossRef]
- Khalil, Z.G.; Kalansuriya, P.; Capon, R.J. Lipopolysaccharide (LPS) Stimulation of Fungal Secondary Metabolism. Mycology 2014, 5, 168–178. [Google Scholar] [CrossRef] [Green Version]
- Raju, R.; Piggott, A.M.; Barrientos Diaz, L.X.; Khalil, Z.; Capon, R.J. Heronapyrroles A-C: Farnesylated 2-Nitropyrroles from an Australian Marine-Derived Streptomyces sp. Org. Lett. 2010, 12, 5158–5161. [Google Scholar] [CrossRef] [PubMed]
- Khalil, Z.G.; Cruz-Morales, P.; Licona-Cassani, C.; Marcellin, E.; Capon, R.J. Inter-Kingdom Beach Warfare: Microbial Chemical Communication Activates Natural Chemical Defences. ISME J. 2019, 13, 147–158. [Google Scholar] [CrossRef]
- Shang, Z.; Salim, A.A.; Khalil, Z.; Quezada, M.; Bernhardt, P.V.; Capon, R.J. Viridicatumtoxins: Expanding on a Rare Tetracycline Antibiotic Scaffold. J. Org. Chem. 2015, 80, 12501–12508. [Google Scholar] [CrossRef] [PubMed]
- Raju, R.; Piggott, A.M.; Huang, X.-C.; Capon, R.J. Nocardioazines: A Novel Bridged Diketopiperazine Scaffold from a Marine-Derived Bacterium Inhibits P-Glycoprotein. Org. Lett. 2011, 13, 2770–2773. [Google Scholar] [CrossRef] [PubMed]
- Shang, Z.; Salim, A.A.; Khalil, Z.; Bernhardt, P.V.; Capon, R.J. Fungal Biotransformation of Tetracycline Antibiotics. J. Org. Chem. 2016, 81, 6186–6194. [Google Scholar] [CrossRef] [PubMed]
- Raju, R.; Piggott, A.M.; Quezada, M.; Capon, R.J. Nocardiopsins C and D and Nocardiopyrone A: New Polyketides from an Australian Marine-Derived Nocardiopsis sp. Tetrahedron 2013, 69, 692–698. [Google Scholar] [CrossRef]
- Raju, R.; Piggott, A.M.; Conte, M.; Tnimov, Z.; Alexandrov, K.; Capon, R.J. Nocardiopsins: New FKBP12-Binding Macrolide Polyketides from an Australian Marine-Derived Actinomycete, Nocardiopsis sp. Chem. Eur. J. 2010, 16, 3194–3200. [Google Scholar] [CrossRef] [PubMed]
- Dekan, Z.; Sianati, S.; Yousuf, A.; Sutcliffe, K.J.; Gillis, A.; Mallet, C.; Singh, P.; Jin, A.H.; Wang, A.M.; Mohammadi, S.A.; et al. A Tetrapeptide Class of Biased Analgesics from an Australian Fungus Targets the Μ-Opioid Receptor. Proc. Natl. Acad. Sci. USA 2019, 116, 22353–22358. [Google Scholar] [CrossRef] [Green Version]
- Yang, J.Y.; Sanchez, L.M.; Rath, C.M.; Liu, X.; Boudreau, P.D.; Bruns, N.; Glukhov, E.; Wodtke, A.; de Felicio, R.; Fenner, A.; et al. Molecular Networking as a Dereplication Strategy. J. Nat. Prod. 2013, 76, 1686–1699. [Google Scholar] [CrossRef] [Green Version]
- Wang, M.; Carver, J.J.; Phelan, V.V.; Sanchez, L.M.; Garg, N.; Peng, Y.; Nguyen, D.D.; Watrous, J.; Kapono, C.A.; Luzzatto-Knaan, T.; et al. Sharing and Community Curation of Mass Spectrometry Data with Global Natural Products Social Molecular Networking. Nat. Biotech. 2016, 34, 828–837. [Google Scholar] [CrossRef] [PubMed] [Green Version]
- Nothias, L.-F.; Nothias-Esposito, M.; da Silva, R.; Wang, M.; Protsyuk, I.; Zhang, Z.; Sarvepalli, A.; Leyssen, P.; Touboul, D.; Costa, J.; et al. Bioactivity-Based Molecular Networking for the Discovery of Drug Leads in Natural Product Bioassay-Guided Fractionation. J. Nat. Prod. 2018, 81, 758–767. [Google Scholar] [CrossRef] [PubMed] [Green Version]
- Elbanna, A.H.; Khalil, Z.G.; Bernhardt, P.V.; Capon, R.J. Scopularides Revisited: Molecular Networking Guided Exploration of Lipodepsipeptides in Australian Marine Fish Gastrointestinal Tract-Derived Fungi. Mar. Drugs 2019, 17, 475. [Google Scholar] [CrossRef] [PubMed] [Green Version]
- Wu, T.; Salim, A.A.; Bernhardt, P.V.; Capon, R.J. Amaurones a-K: Polyketides from the Fish Gut-Derived Fungus Amauroascus sp. CMB-F713. J. Nat. Prod. 2021, 84, 474–482. [Google Scholar] [CrossRef] [PubMed]
- Rutledge, P.J.; Challis, G.L. Discovery of Microbial Natural Products by Activation of Silent Biosynthetic Gene Clusters. Nat. Rev. Microbiol. 2015, 13, 509–523. [Google Scholar] [CrossRef] [PubMed]
- Teijaro, C.N.; Adhikari, A.; Shen, B. Challenges and Opportunities for Natural Product Discovery, Production, and Engineering in Native Producers Versus Heterologous Hosts. J. Ind. Microbiol. Biotechnol. 2019, 46, 433–444. [Google Scholar] [CrossRef] [PubMed]
- Ruiz, B.; Chávez, A.; Forero, A.; García-Huante, Y.; Romero, A.; Sánchez, M.; Rocha, D.; Sánchez, B.; Rodríguez-Sanoja, R.; Sánchez, S.; et al. Production of Microbial Secondary Metabolites: Regulation by the Carbon Source. Crit. Rev. Microbiol. 2010, 36, 146–167. [Google Scholar] [CrossRef]
- Paranagama, P.A.; Wijeratne, E.M.K.; Gunatilaka, A.A.L. Uncovering Biosynthetic Potential of Plant-Associated Fungi: Effect of Culture Conditions on Metabolite Production by Paraphaeosphaeria quadriseptata and Chaetomium chiversii. J. Nat. Prod. 2007, 70, 1939–1945. [Google Scholar] [CrossRef]
- Bode, H.B.; Bethe, B.; Höfs, R.; Zeeck, A. Big Effects from Small Changes: Possible Ways to Explore Nature’s Chemical Diversity. Chem. Biol. Chem. 2002, 3, 619–627. [Google Scholar] [CrossRef]
- Khalil, Z.G.; Salim, A.A.; Capon, R.J. Microbioreactor Techniques for the Production and Spectroscopic Characterization of Microbial Peptides. In Peptide Synthesis: Methods and Protocols; Hussein, W.M., Skwarczynski, M., Toth, I., Eds.; Springer: New York, NY, USA, 2020; pp. 303–322. [Google Scholar]
- Dewapriya, P.; Khalil, Z.G.; Prasad, P.; Salim, A.A.; Cruz-Morales, P.; Marcellin, E.; Capon, R.J. Talaropeptides A-D: Structure and Biosynthesis of Extensively N-Methylated Linear Peptides from an Australian Marine Tunicate-Derived Talaromyces sp. Front. Chem. 2018, 6, 394/1–394/15. [Google Scholar] [CrossRef]
- Mohamed, O.G.; Khalil, Z.G.; Salim, A.A.; Cui, H.; Blumenthal, A.; Capon, R.J. Lincolnenins A–D: Isomeric Bactericidal Bianthracenes from Streptomyces lincolnensis. J. Org. Chem. 2020, 86, 11011–11018. [Google Scholar] [CrossRef] [PubMed]
- Kalansuriya, P.; Quezada, M.; Esposito, B.P.; Capon, R.J. Talarazines A-E: Noncytotoxic Iron(Iii) Chelators from an Australian Mud Dauber Wasp-Associated Fungus, Talaromyces sp. (CMB-W045). J. Nat. Prod. 2017, 80, 609–615. [Google Scholar] [CrossRef]
- Capon, R.J. Extracting Value: Mechanistic Insights into the Formation of Natural Product Artifacts-Case Studies in Marine Natural Products. Nat. Prod. Rep. 2020, 37, 55–79. [Google Scholar] [CrossRef]
- Shang, Z.; Raju, R.; Salim, A.A.; Khalil, Z.G.; Capon, R.J. Cytochalasins from an Australian Marine Sediment-Derived Phomopsis sp. (CMB-M0042F): Acid-Mediated Intramolecular Cycloadditions Enhance Chemical Diversity. J. Org. Chem. 2017, 82, 9704–9709. [Google Scholar] [CrossRef]
- Mohamed, O.G.; Khalil, Z.G.; Capon, R.J. Prolinimines: N-Amino-L-Pro-Methyl Ester (Hydrazine) Schiff Bases from a Fish Gastrointestinal Tract-Derived Fungus, Trichoderma sp. CMB-F563. Org. Lett. 2018, 20, 377–380. [Google Scholar] [CrossRef]
- Mohamed, O.G.; Khalil, Z.G.; Capon, R.J. N-Amino-L-Proline Methyl Ester from an Australian Fish Gut-Derived Fungus: Challenging the Distinction between Natural Product and Artifact. Mar. Drugs 2021, 19, 151. [Google Scholar] [CrossRef] [PubMed]
- Wang, Q.; Song, F.; Xiao, X.; Huang, P.; Li, L.; Monte, A.; Abdel-Mageed, W.M.; Wang, J.; Guo, H.; He, W.; et al. Abyssomicins from the South China Sea Deep-Sea Sediment Verrucosispora sp.: Natural Thioether Michael Addition Adducts as Antitubercular Prodrugs. Angew. Chem. Int. Ed. 2013, 52, 1231–1234. [Google Scholar] [CrossRef] [PubMed] [Green Version]
- Khalil, Z.G.; Huang, X.-C.; Raju, R.; Piggott, A.M.; Capon, R.J. Shornephine A: Structure, Chemical Stability, and P-Glycoprotein Inhibitory Properties of a Rare Diketomorpholine from an Australian Marine-Derived Aspergillus sp. J. Org. Chem. 2014, 79, 8700–8705. [Google Scholar] [CrossRef] [PubMed] [Green Version]

Publisher’s Note: MDPI stays neutral with regard to jurisdictional claims in published maps and institutional affiliations. |
© 2021 by the authors. Licensee MDPI, Basel, Switzerland. This article is an open access article distributed under the terms and conditions of the Creative Commons Attribution (CC BY) license (https://creativecommons.org/licenses/by/4.0/).
Share and Cite
Salim, A.A.; Khalil, Z.G.; Elbanna, A.H.; Wu, T.; Capon, R.J. Methods in Microbial Biodiscovery. Mar. Drugs 2021, 19, 503. https://doi.org/10.3390/md19090503
Salim AA, Khalil ZG, Elbanna AH, Wu T, Capon RJ. Methods in Microbial Biodiscovery. Marine Drugs. 2021; 19(9):503. https://doi.org/10.3390/md19090503
Chicago/Turabian StyleSalim, Angela A., Zeinab G. Khalil, Ahmed H. Elbanna, Taizong Wu, and Robert J. Capon. 2021. "Methods in Microbial Biodiscovery" Marine Drugs 19, no. 9: 503. https://doi.org/10.3390/md19090503
APA StyleSalim, A. A., Khalil, Z. G., Elbanna, A. H., Wu, T., & Capon, R. J. (2021). Methods in Microbial Biodiscovery. Marine Drugs, 19(9), 503. https://doi.org/10.3390/md19090503

